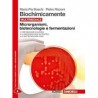
9788808135896

- -50%
- Non disponibile

9788808135896 Biochimicamente. Microrganismi, biotecnologie e fermentazioni Boschi Rizzoni
Spedizione entro 24/48 ore. Consegna a seconda del servizio scelto dall'utente.

Pagamento su Server Sicuro. PAYPAL e carte, Bonifico o Postepay.
Libro Controllato e Garantito. Controlla la nostra Legenda di valutazione stato del libro.
Biochimicamente. Microrganismi, biotecnologie e fermentazioni Boschi Rizzoni Zanichelli 9788808135896
Scheda tecnica
Riferimenti Specifici